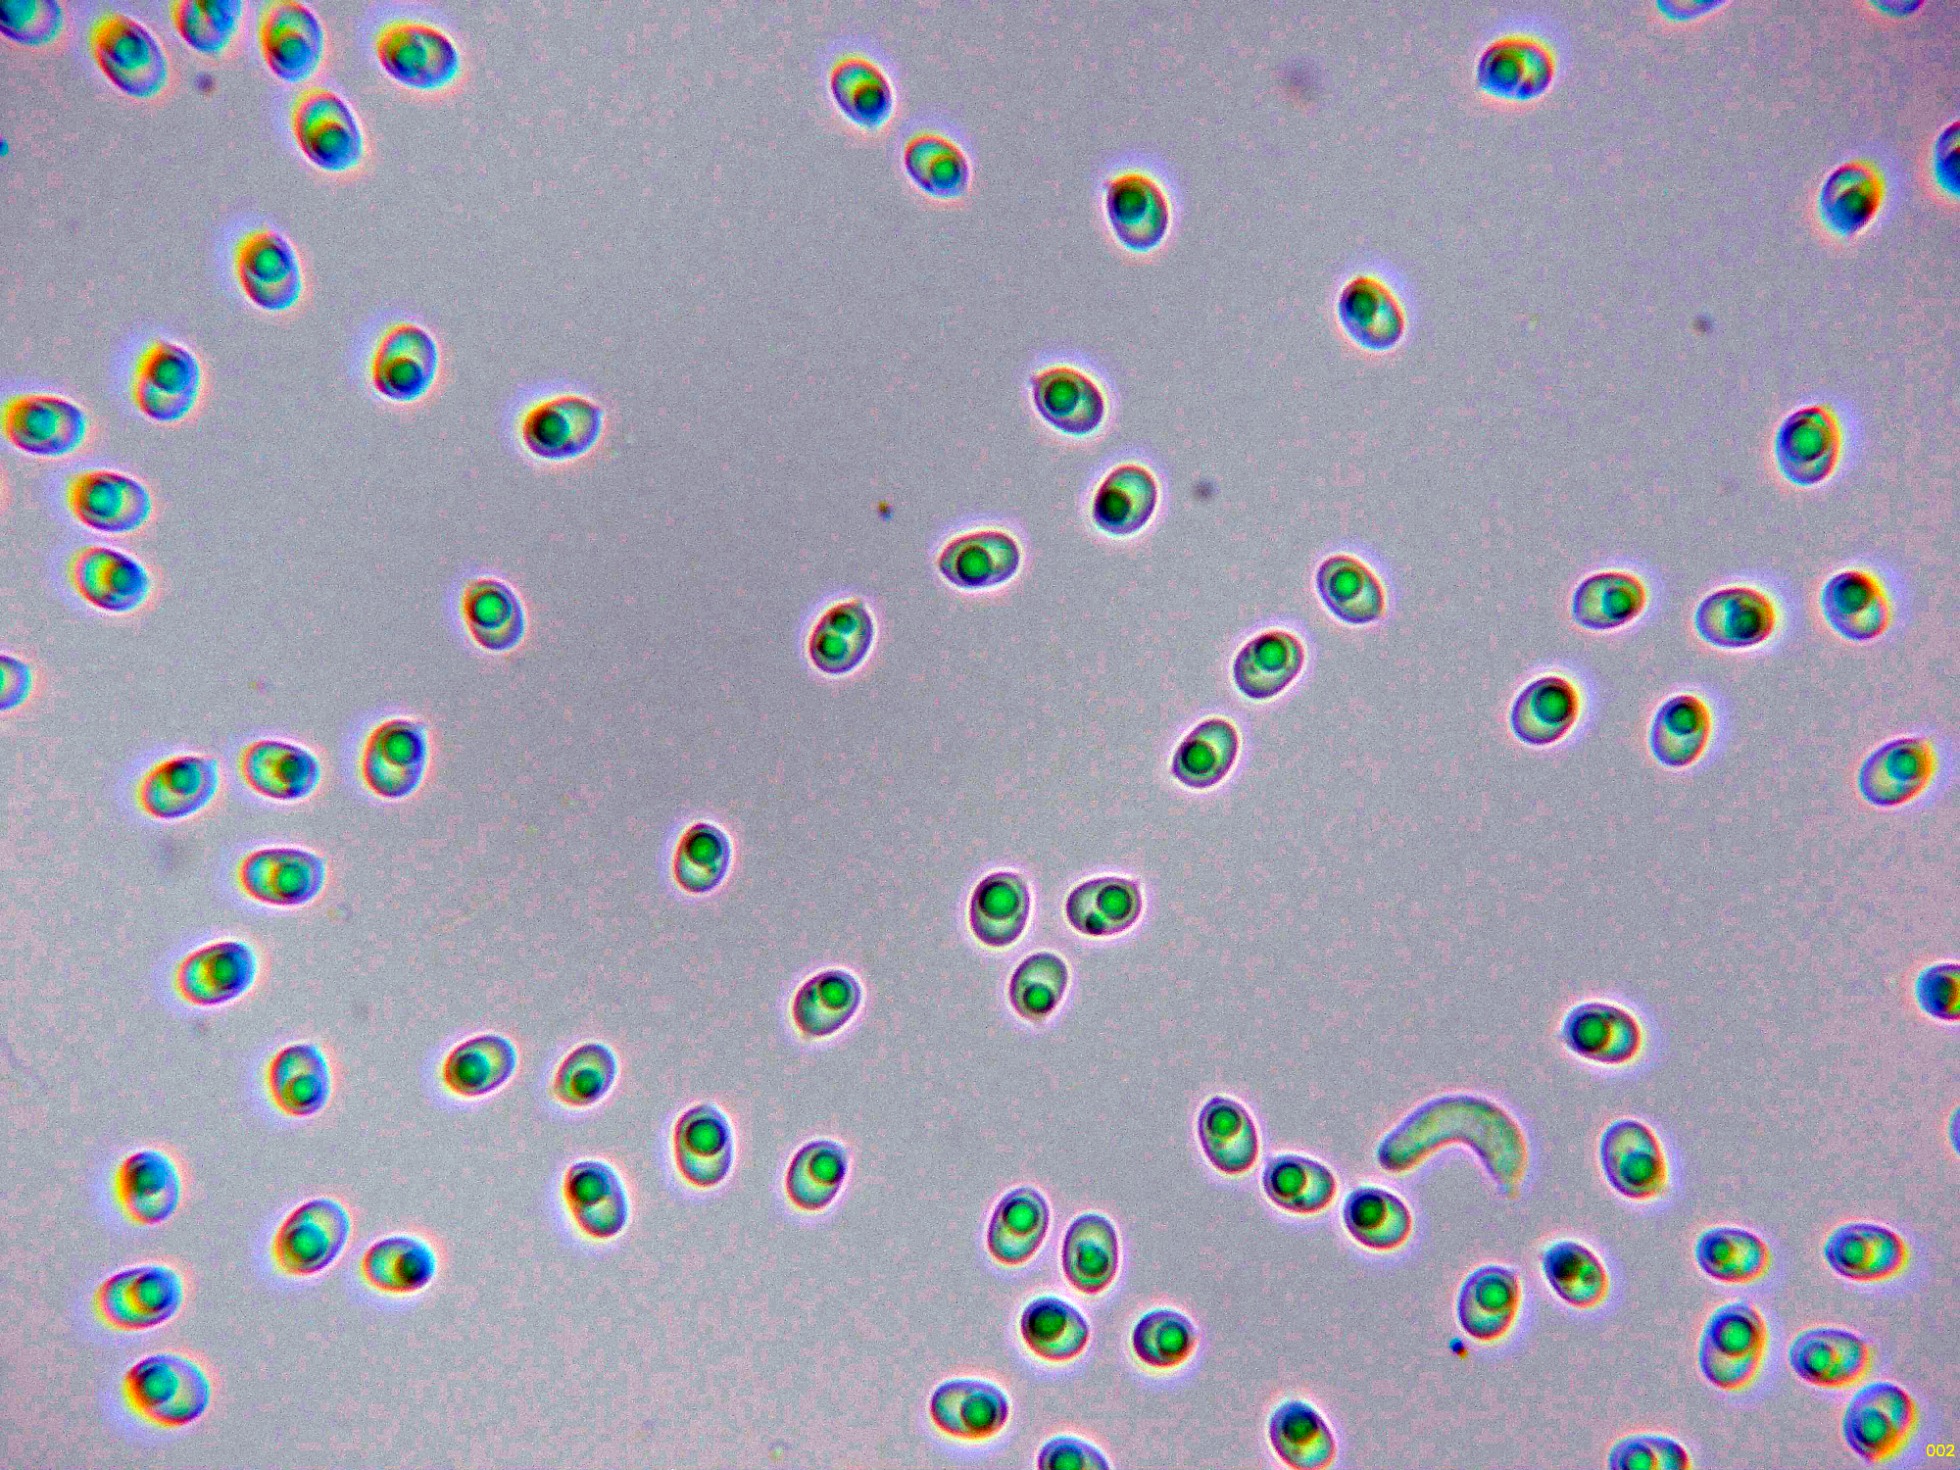

El monte empieza a despertar.
El monte empieza a despertar.
- Josep Torres
-
 Autor del tema
Autor del tema
- Fuera de línea
- Moderador
-

Menos
Más
- Mensajes: 8746
- Gracias recibidas: 8379
2 años 1 mes antes - 2 años 1 mes antes #109869
por Josep Torres
El monte empieza a despertar. Publicado por Josep Torres
Hola a tod@s.
Con las lluvias de estos últimos días, parece que la cosa comienza a animarse, lástima que ahora con un par de días de viento, volverá a quedar todo seco.
Pongo lo que pude ver este pasado domingo en cauce fluvial y a 250 msnm.
Todo de especies que ya había estudiado con anterioridad.
En la cuneta y al borde de la carretera, un Agaricus que atendiendo a su carne prácticamente inmutable al corte, su corto pie (menos del diámetro del sombrero) y la microscopía obtenida apunta a lo que en sentido amplio podemos considerar como Agaricus campestris sl.
La arista laminar.
Los basidios tetraspóricos.
Y las esporas.
Estas esporas con unas medidas de:
(6.8) 6.9 - 7.9 (8.2) × (4.6) 5.1 - 6.1 (6.2) µm
Q = (1.2) 1.22 - 1.4 (1.6) ; N = 24
Me = 7.3 × 5.5 µm ; Qe = 1.3
Un Crepidotus, con esporas entre esféricas y subglobosas, tímidamente verrucosas, el Crepidotus cesatii, cuarto estudio que realizo a la especie.
Hifas de la suprapellis, separadas por gelificación y fibuladas.
Los queilocistidios.
Los basidios tetraspóricos.
Las esporas en agua.
Estas esporas obtenidas por esporulación natural y en agua con unas medidas de:
(6.6) 7.1 - 8.7 (9.1) × (5.4) 5.6 - 6.5 (6.7) µm
Q = (1.1) 1.2 - 1.4 (1.5) ; N = 30
Me = 8 × 6 µm ; Qe = 1.3
Un Mixomiceto, por unos instantes hasta creí que podría ser interesante, nada más lejos que la realidad, décimo estudio que realizo a la especie, el muy abundante y omnipresente Physarum album.
A 20 aumentos.
A 40 aumentos con sus medidas.
El capilicio.
Y las esporas.
Estas esporas con unas medidas de:
(7.9) 8.3 - 9.2 (9.3) × (7.8) 8.1 - 8.9 (9) µm
Q = 1 - 1.07 (1.1) ; N = 30
Me = 8.8 × 8.5 µm ; Qe = 1
Un Corticial, que a pesar de lo que nos sugiere su nombre, no estaría asociado solo a Sambucus, sinó que lo podemos encontrar sobre múltiples sustratos, incluso me lo he encontrado sobre la caña común (Arundo donax), octavo estudio realizado a la especie, la Hyphodontia sambuci = Xylodon sambuci, que atendiendo al criterio de Index Fungorum, actualmente la debemos denominar como Lyomyces sambuci.
Superficie del basidioma a 20 aumentos.
Las hifas subiculares con fíbulas.
Sus cistidios capitados.
Los basidios, con 4 o más esterigmas.
Las esporas obtenidas por esporulación natural y en agua.
Estas esporas con unas medidas de:
(4.8) 5.1 - 5.5 (5.7) × (3.6) 3.7 - 4 (4.2) µm
Q = 1.3 - 1.4 (1.5) ; N = 30
Me = 5.3 × 3.9 µm ; Qe = 1.4
Y ya sin microscopía, unas cuantas que a pie de campo tenía ya muy clara su identidad:
Muy abundante y colonizando todos los troncos del suelo, la Auricularia mesenterica.
Fino como el papel, con himenio meruloide, el Byssomerulius corium.
Uno que si bien según la bibliografía no se considera para nada común, es muy abundante por los alrededores de mi ciudad, la inconfundible Auriculariopsis ampla, actualmente Schizophyllum amplum.
Y para terminar una imágen de la siempre vistosa, Tremella mesenterica.
Saludos a tod@s.
Con las lluvias de estos últimos días, parece que la cosa comienza a animarse, lástima que ahora con un par de días de viento, volverá a quedar todo seco.
Pongo lo que pude ver este pasado domingo en cauce fluvial y a 250 msnm.
Todo de especies que ya había estudiado con anterioridad.
En la cuneta y al borde de la carretera, un Agaricus que atendiendo a su carne prácticamente inmutable al corte, su corto pie (menos del diámetro del sombrero) y la microscopía obtenida apunta a lo que en sentido amplio podemos considerar como Agaricus campestris sl.
La arista laminar.
Los basidios tetraspóricos.
Y las esporas.
Estas esporas con unas medidas de:
(6.8) 6.9 - 7.9 (8.2) × (4.6) 5.1 - 6.1 (6.2) µm
Q = (1.2) 1.22 - 1.4 (1.6) ; N = 24
Me = 7.3 × 5.5 µm ; Qe = 1.3
Un Crepidotus, con esporas entre esféricas y subglobosas, tímidamente verrucosas, el Crepidotus cesatii, cuarto estudio que realizo a la especie.
Hifas de la suprapellis, separadas por gelificación y fibuladas.
Los queilocistidios.
Los basidios tetraspóricos.
Las esporas en agua.
Estas esporas obtenidas por esporulación natural y en agua con unas medidas de:
(6.6) 7.1 - 8.7 (9.1) × (5.4) 5.6 - 6.5 (6.7) µm
Q = (1.1) 1.2 - 1.4 (1.5) ; N = 30
Me = 8 × 6 µm ; Qe = 1.3
Un Mixomiceto, por unos instantes hasta creí que podría ser interesante, nada más lejos que la realidad, décimo estudio que realizo a la especie, el muy abundante y omnipresente Physarum album.
A 20 aumentos.
A 40 aumentos con sus medidas.
El capilicio.
Y las esporas.
Estas esporas con unas medidas de:
(7.9) 8.3 - 9.2 (9.3) × (7.8) 8.1 - 8.9 (9) µm
Q = 1 - 1.07 (1.1) ; N = 30
Me = 8.8 × 8.5 µm ; Qe = 1
Un Corticial, que a pesar de lo que nos sugiere su nombre, no estaría asociado solo a Sambucus, sinó que lo podemos encontrar sobre múltiples sustratos, incluso me lo he encontrado sobre la caña común (Arundo donax), octavo estudio realizado a la especie, la Hyphodontia sambuci = Xylodon sambuci, que atendiendo al criterio de Index Fungorum, actualmente la debemos denominar como Lyomyces sambuci.
Superficie del basidioma a 20 aumentos.
Las hifas subiculares con fíbulas.
Sus cistidios capitados.
Los basidios, con 4 o más esterigmas.
Las esporas obtenidas por esporulación natural y en agua.
Estas esporas con unas medidas de:
(4.8) 5.1 - 5.5 (5.7) × (3.6) 3.7 - 4 (4.2) µm
Q = 1.3 - 1.4 (1.5) ; N = 30
Me = 5.3 × 3.9 µm ; Qe = 1.4
Y ya sin microscopía, unas cuantas que a pie de campo tenía ya muy clara su identidad:
Muy abundante y colonizando todos los troncos del suelo, la Auricularia mesenterica.
Fino como el papel, con himenio meruloide, el Byssomerulius corium.
Uno que si bien según la bibliografía no se considera para nada común, es muy abundante por los alrededores de mi ciudad, la inconfundible Auriculariopsis ampla, actualmente Schizophyllum amplum.
Y para terminar una imágen de la siempre vistosa, Tremella mesenterica.
Saludos a tod@s.
Adjuntos:
Última Edición: 2 años 1 mes antes por Josep Torres. Razón: Una falta de ortografía
El siguiente usuario dijo gracias: Juan
Por favor, Identificarse para unirse a la conversación.
- Juan Andrés Román
-

- Fuera de línea
- Spammer
-

Menos
Más
- Mensajes: 2558
- Gracias recibidas: 2756
2 años 1 mes antes #109875
por Juan Andrés Román
Respuesta de Juan Andrés Román sobre el tema El monte empieza a despertar.
Por lo menos ya empieza a salir algo de material ..........................
Un abrazo Josep.
Un abrazo Josep.
El siguiente usuario dijo gracias: Josep Torres, Juan
Por favor, Identificarse para unirse a la conversación.
- Josep Torres
-
 Autor del tema
Autor del tema
- Fuera de línea
- Moderador
-

Menos
Más
- Mensajes: 8746
- Gracias recibidas: 8379
2 años 1 mes antes #109878
por Josep Torres
Respuesta de Josep Torres sobre el tema El monte empieza a despertar.
El siguiente usuario dijo gracias: Juan
Por favor, Identificarse para unirse a la conversación.
- Juan
-

- Fuera de línea
- Moderador
-

Menos
Más
- Mensajes: 553
- Gracias recibidas: 608
2 años 3 semanas antes #109886
por Juan
Respuesta de Juan sobre el tema El monte empieza a despertar.
Excelente trabajo Josep como siempre 
El siguiente usuario dijo gracias: Josep Torres
Por favor, Identificarse para unirse a la conversación.
Tiempo de carga de la página: 0.341 segundos

Foro de micología